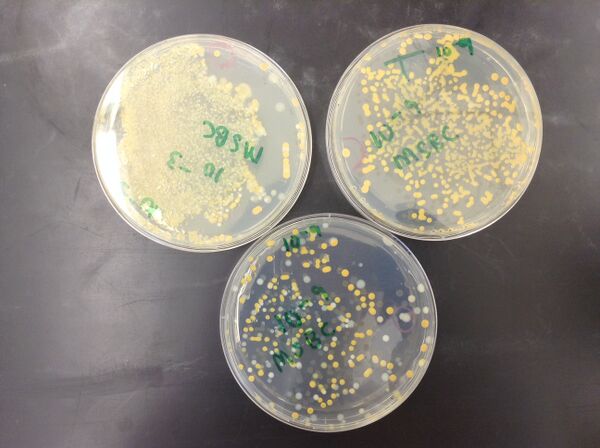

User:Bickey Chang/Notebook/Biology 210 at AU
Jul 28, 2014
Bacterial Species Identified in Transect 1
Introduction
In Lab 3, we characterized bacteria colonies from Transect 1 which grew on nutrient and tetracycline plates. We also performed Gram staining of three selected colonies and described their motility, shape, and arrangement. In this lab, we received the 16s rRNA sequences of bacteria found in Transect 1 and will compare the identified bacteria with our prior observations.
Materials and Methods
Secondary data was obtained from 16s sequencing results of bacteria collected from Transect 1. The sequences were copied into NCBI's Basic Local Alignment Search Tool (BLAST) "nucleotide blast" and the closest match was identified. The sequencing results were compared with prior observations
Results
Three types of bacteria were identified from the sequencing results from Transect 1. They are Methylobacterium, Chryseobacterium, and Pseudomonas. All three types are commonly found in soil and water. Common characteristics include Gram negative stain and rod-shaped. It is notable that Chryseobacterium has resistance to tetracycline.
Table 1 presents these three bacteria.
Table 1 Three Bacteria Identified from Transect 1
| Bacteria | Gram + or - | Shape | Description |
|---|---|---|---|
| Methylobacterium | Gram - | Rod | Colony pale pink to bright orange red |
| Chryseobacterium | Gram - | Rod | Has resistance to tetracycline |
| Pseudomonas | Gram - | Rod | Pathogen of plants, single flagellum |
Table 1 shows three bacteria were sequenced from Transect 1: Methylobacterium, Chryseobacterium, and Pseudomonas. (Fackrell, 2014; Todar, 2014; Abell, 2005)
Table 2 recaps our prior observations.
Table 2 Characterization of Three Bacterial Colonies
| Colony Label | Plate type | Colony Description | Bacteria Description |
|---|---|---|---|
| A | Nutrient, 10^(-3) | Yellow, circular, convex, even (entire) | Gram -, stained dark orange, spherical, 3.3 um |
| B | Nutrient, 10^(-9) | White, filamentous, convex | Gram +, stained purple, spherical, 10 um |
| C | Tetracycline, 10^(-9) | Yellow, circular, convex, curled | Gram +, stained purple, spherical, 10 um |
Table 2 shows the three bacterial colonies are yellow and white, with a convex shape. Individual bacteria had a circular morphology and a size of between 3.3 um to 10um.
Discussion
The three bacteria identified through sequencing were all Gram negative, rod-shaped strains. However, the bacteria observed were all spherical and only one strain was Gram positive. None of the strains identified through sequencing matched the observed strains exactly. However, some common characteristics were observed in both, such as the resistance to tetracycline observed in observed bacteria C and in the sequenced Chryseobacterium. The three bacteria identified were all commonly found strains in soil and water, which also suggest they could thrive in Transect 1.
The bacteria collected for sequencing was done in the spring prior to the observation. The temporal difference may have contributed to the observation of different strands of bacteria. It is notable that Transect 1 very likely contains more than only three strains of bacteria. Therefore, the differences between the sequencing results and the observed results also highlight the amount of diversity which may be present in Transect 1.
References
1. Fackrell, Hugh. 2014. Methylobacterium. University of Windsor. Accessed Jul 28 2014 from http://web2.uwindsor.ca/courses/biology/fackrell/Microbes/4440.htm
2. Todar, Kenneth. 2014. Pseudomonas. Todar's Online Textbook of Bacteriology. Accessed Jul 28 2014 from http://textbookofbacteriology.net/pseudomonas.html
3. Abell, Guy, and Bowman, John. 2005. Ecological and biogeographic relationships of class Flaveobacteria in the Southern Ocean. FEMS Microbiology Ecology. 51(2):265-77
Jul 15, 2014
Lab 5: Invertebrates and Vertebrates
Introduction
Invertebrates are a diverse paraphletic group of organisms which contain fourteen different phyla. (Freeman, 2014) More than a million species of anthropods have been identified but many more remain unidentified. The simplest animals are sponges from the invertebrate phylum Porifera. Sponges do not yet have tissues but cells are associated with each other. True tissue is found in all other animals. Primitive invertebrates, including Cnidaria and Ctenophora, have radial symmetry and only two types of embryonic tissue, the ectoderm and endoderm. Bilateral symmetry evolved from these primitive invertebrates and a third type of embryonic tissue could be found in these organisms, leading to the formation of systems of organizing internal organs and tissues. (Bentley et. al, 2014)
Vertebrates are a monophyletic group of animals with backbones which comprise of most animals humans are most familiar with, including fishes, amphibians, mammals, and reptiles. The vertebrae and the cranium are two synapomorphies which distinguish vertebrates. Evolutionary innovations in vertebrates include the vertebrate jaw, the tetrapod limb, the amniotic egg, the placenta, parental care, and wings and flight.(Freeman, 2014)
A food web In this lab we examine four invertebrates found from the leaf litter in Trasect 1 and identify them using a dichotomous key. We hypothesize most invertebrates found will be insects in the class of Anthropoda invertebrates. We also construct a food web to synthesize the biome which is present in Transect 1.
Materials and Methods
The Berlese funnel was taken apart and contents in the ethanol tube were poured into two petri dishes. The two petri dishes were examined under the microscope to search for invertebrates, which were then transferred onto slides for microscopic observation under 40x magnification. Organisms were measured using an ocular micrometer and number in the sample was recorded. Organisms were also characterized and identified using a dichotomous key.
Results
Multiple small invertebrates were found floating on the ethanol poured from the Berlese funnel. (Figure 1)
Figure 1 Photograph of Invertebrates from the Berlese Funnel
Figure 1 shows invertebrates which were collected using the Berlese funnel.
Four invertebrates were identified from the leaf litter sample from Transect 1: Sucking lice (Anoplura), termite (Isoptera), flea (Siphonaptera), and a small millipede-like organism. There was variety in the size of organisms, with an observed range from 0.375 mm (termite) to 3.75 mm (millipede-like organism). Sucking lice and termites were most common in the leaf litter. Table 1 presents a summary of the four organisms.
Table 1 Summary of Four Invertebrates from Transect 1
| Organism | Length | Number in sample | Description |
|---|---|---|---|
| Sucking lice (Anoplura) | 3mm | 20 | Long, brown, six legs, has many segments, has visible feeding structure |
| Termite (Isoptera) | 0.375mm | 61 | Short, light brown, eight legs, round |
| Flea (Siphonaptera) | 2.75mm | 1 | Compressed, brown, six legs, long antenna, segmented, hariy |
| Millipede-like organisms | 3.75mm | 1 | Long, brown with black dots, many very thin legs, segmented |
Table 1 summarizes characteristics of four invertebrates found in Transect 1. Sucking lice and termite were the most commonly found organisms.
Figure 2 Photograph of Sucking Lice
Figure 2 shows a photograph of sucking lice under 40x magnification.
Figure 3 Drawing of Termite
Figure 3 shows a drawing of termite under 40x magnification.
Figure 4 Photograph of Flea
Figure 4 shows a photograph of flea under 40x magnification.
Figure 5 Photograph of Millipede-like Organism
Figure 5 shows a photograph of a millipede-like organism under 40x magnification.
Table 2 shows five vertebrates that may inhabit the transect and how they can utilize the biotic and abiotic characteristics of the transect to benefit life.
Table 2 Five Possible Vertebrates Species in Transect 1
| Organism | Classification | Biotic and abiotic benefits | Reference |
|---|---|---|---|
| Robin | Chordata Aves Passeriformes Turdidae Turdus migratorius | invertebrates, seeds, berries for food | (Turdus migratorius, 2014) |
| Crow | Chordata Aves Passeriformes Corvidae Corvus brachyrhynchos | invertebrates, seeds, mice for food and food from humans | (Corvus brachyrhynchos, 2014) |
| Squirrel | Chordata Mammalia Rodentia Sciuridae carolinensis | flowers, seeds, berries for food and food from humans; grass for hiding | (Sciuridae carolinensis, 2014) |
| Mouse | Chordata Mammalia Rodentia Muridae Mus musculus | flowers, seeds, berries for food and food from humans; grass for hiding | (Mus musculus, 2014) |
| Frog | Chordata Amphibia Anura Hylidae Hyla cinerea | invertibrates for food | (Hyla cinera, 2014) |
Table 2 shows five potential vertebrate species which may inhabit Transect 1.
Discussion
Multiple types of invertebrates were observed from Transect 1. Additional invertebrates were isolated using the Berlese funnel but were not characterized. Characterization of invertebrates was often difficult using the dichotomous key because answers did not always correspond with observed characteristics, reflecting the diversity of invertebrates.
Vertebrates were not observed directly from the transect, but animals common in residential areas in this area and in marshes could potentially thrive in the transect.
Groups of organisms which have been observed in Transect 1 make up the community of Transect 1. A community is the sum of all species in an area which interact with each other. (Freeman, 2014) A food web can be constructed to depict one way the organisms in this community interact with one another. (Figure 6)
Figure 6 Food Web in Transect 1
Figure 6 shows a food web of observed organisms in Transect 1.
As shown in Figure 6, organisms are on different trophic levels, or feeding levels. Photosynthesizing land plants are the primary producers, and bacteria are decomposers. Vertebrates and invertebrates are consumers at different levels, further illustrating the diversity that can be seen in these groups of organisms. The concept of carrying capacity, or the maximum population size a habitat can sustain, should be considered when examining the food web for Transect 1. (Freeman, 2014) We did not observe any vertebrates utilizing Transect 1 as their permanent and only home, suggesting that the resources on Transect 1 may not be enough to support a large number of vertebrates. Instead, vertebrates utilized resources from Transect 1 but also sought additional food sources from other parts of campus to fulfill their needs.
It is notable that the observed organisms provide just a snapshot of organisms which are present on Transect 1. Further study can provide a more comprehensive understanding of how organisms interact in this mini ecosystem and how it is sustainable and stable.
References
1. Bentley, Walters-Conte, & Zeller. 2014. Biology 210 Laboratory: The Diversity of Life Lab Manual. American University: Washington.
2. Freeman, Scott. 2014. Biological Science. Prentice Hall: Boston.
3. 2014. Turdus migratorius. Encyclopedia of Life. Accessed Jul 16 2014 from http://eol.org/pages/1177506/overview
4. 2014. Corvus brachyrhynchos. Encyclopedia of Life. Accessed Jul 16 2014 from http://eol.org/pages/1177464/overview
5. 2014. Sciurus carolinensis. Smithsonian National Museum of Natural History. Accessed Jul 16 2014 from http://www.mnh.si.edu/mna/image_info.cfm?species_id=298
6. 2014. Mus musculus. Encyclopedia of Life. Accessed Jul 16 2014 from http://eol.org/pages/328450/overview
7. 2014. Hyla cinerea. Encyclopedia of Life. Accessed Jul 16 2014 from http://eol.org/pages/1025215/overview
Jul 10, 2014
Lab 4: Plantae and Fungi
Introduction
Algae is the ancestor from which land plants evolved. Together, algae and land plants are referred to as Plantae. The Plantae subgroups descend from a common ancestor that performed endosymbiosis of a cyanobacterium, leading to the evolution of the chloroplast. Chloroplast is a distinguishing feature which would contribute to the rapid growth of oxygen in Earth's atmosphere and provide the opportunity for radiation of new species. (Freeman, 2014)
There are four major phyla of land plants: Bryophytes, Tracheophytes, Gymnosperms, and Angiosperms. Bryophytes are small, non-vascular plants, such as moss. Tracheophytes have an early vascular system. Subsequently, land plants evolved to have seeds and flowers. Gymnosperms are seed plants, such as redwoods and pines. Angiosperms are flowering plants which have the ability to spread pollen and reproduce in new niches. (Bentley et. al, 2014)
Fungi are an important part of the biosphere. As decomposers, they are essential to the carbon and nitrogen cycles. Though fungi can be unicellular, most are composed of multiple filaments and are highly structured. (Bentley et. al, 2014)
In this lab, we will collect five plant samples from Transect 1 and analyze their vascularization, cell specialization, and reproduction. We will also observe fungi. We hypothesize that there will a variety of different plants which live together in the mini marsh Transect.
Materials and Methods
Samples from five different plants from Transect 1 were collected. The locations where the samples were collected from were documented and photos of the collected plants were taken. The plants were observed for vascularization, cell specialization, and reproduction.
Samples of fungi were viewed under a microscope.
A 500g leaf litter sample of dead leaves from different areas of the transect was also collected. A Berlese Funnel was set up to collect invertibrates. 25 ml of ethanol was added to a 50 ml tube. A funnel was held by a ring stand on top of the ethanol, and a piece of screening material was fixed into a funnel to prevent leaf litter from falling into the ethanol. The funnel and tube containing ethanol were Parafilmed together to prevent ethanol evaporation. Leaf litter was poured into the funnel, and a 40-watt light was shined above the funnel. The Berlese Funnel set up was covered with aluminum foil and set aside for four days.
Results
Five samples of different plants were collected from different areas of the transect, as shown in Figure 1. A summary of the five plants, as presented in Table 1, show that though there is variation, all are vascular with leaf structures and most are dicots.
Figure 1 Location of Five Sample Plants on Transect 1
Figure 1 shows the locations on the transect where the five sample plants were collected.
Figure 2 Photograph of Five Sample Plants from Transect 1
Figure 2 shows the morphology of Five Sample Plants from Transect 1. Note the cat tail was also included to exemplify the diversity which exists on Transect 1 that could not be fully captured by the five samples.
Table 1 Summary of Five Sample Plants from Transect 1
| Sample number | Description | Vascularization | Specialized structures | Reproduction |
|---|---|---|---|---|
| 1 | White flower with five petals | Yes | Leaves, stomata | Flower, dicot |
| 2 | Blue-stemmed grass with long leaves and small seeds | Yes | Leaves, no visible stomata | Seed, dicot, no flower |
| 3 | Berry-like plant with red stem, green berries, and large leaves | Yes | Leaves | Seed, dicot, no flower |
| 4 | Water plant with pink flowers, small leaves, and many green branches | Yes | Leaves, not waxy | Flower, dicot |
| 5 | Fern-like plant with long, green leaves | Yes | Leaves | Not observed |
Table 1 provides a summary of five plants collected from Transect 1. All plants had vascularization and leaves. Most plants were dicot.
Sample 1 and 4 had vascular structures and visible flowers. (Figure 3) They are examples of angiosperms from Transect 1. Dissection of the white flowers from Sample 1 showed dicot ovaries, under the microscope, the microsporangium in the stamen could be observed. Dissection of the pink flowers from Sample 4 showed visible microsporangium in the stamen under the microscope.
Figure 3 Photograph of dissected flowers from Sample 1 and 4
Figure 3 is a photograph of dissected flowers from Sample 1 and 4. Ovaries and stamen could be observed.
Sample 2 and 3 had vascular structures, seeds, and no visible flowers. They are examples of gymnosperms. Dissection of the seeds showed two small cotyledon. (Figure 4)
Figure 4 Photograph of a dissected berry seed from Sample 3
Figure 4 is a photograph of a dissected berry seed from Sample 4. Two small cotyledon could be seen clearly.
Sample 5 had vascular structures but with no visible seeds nor flowers. It is an example of pteridophyta.
All samples were vascular plants with visible vascular structures in the stem and the leaves of the plants. Viewed under the microscope, vascular bundles were found to be organized in a ring instead of scattered. All samples had leaves which were long and thin with networks of veins.
Observation of fungi samples under the microscope show filamentous hyphae threads with small spherical sporangia structures. (Figure 5)
Figure 5 Observation of Rhizopius Zigospores at 400x Magnification
Figure 5 shows Rhizopius zigospores under the microscope at 400x magnification. Hyphae and sporangia can be observed.
Discussion
In this lab, we hypothesized that there will a variety of different plants which live together in the mini marsh Transect. The range of plants collected confirmed this hypothesis. In addition, observation of the map shows that many additional forms of plant life were present on this transect. Due to time constraints, only five samples could be analyzed. Though they are not entirely representative of the diversity which is present on the transect, they represent three different phyla of plants - the seedless plants, gymnosperms seed plants, and angiosperm seed plants. Further observation is needed to characterize the full diversity of plant life on Transect 1.
Fungi was not observed on the transect. We viewed Rhizopius under the microscope and distinguished hyphae and sporangia structures, which are defining characteristics of fungi. The sporangia are important structures in fungi reproduction because they contain spores which can be released when the sporangia bursts open. The spread of spores is important for fungi reproduction. (Bentley, 2014)
References
1. Bentley, Walters-Conte, & Zeller. 2014. Biology 210 Laboratory: The Diversity of Life Lab Manual. American University: Washington.
2. Freeman, Scott. 2014. Biological Science. Prentice Hall: Boston.
Jul 7, 2014
Lab 3: Microbiology and Identifying Bacteria with DNA Sequences
Introduction
Living organisms on earth can be divided into prokaryotes, eukaryotes, and archaea. In the previous lab, we studied unicellular organisms from the domain eukarya. In this lab, we aim to study prokaryotes in domain bacteria which were found in Transect 1 and cultured on agar last week. Since arachea tend to grow in extreme environments, we do not anticipate any archaea species will have grown on the agar plates. (Bentley et. al, 2014) Bacteria and archaea are mostly unicelluar and all prokaryotic, without membrane-bound nucleus and organelles. (Freeman, 2014)
Antibiotics were discovered in 1928 to combat bacteria which caused diseases and infections in humans by killing them or stopping them from growing. Different types of antibiotics can have different effects on different types of bacteria. Some bacteria have also evolved to have drug-resistance which allow them to grow in antibioitics and even use antibiotics as a food source. (Freeman, 2014). Tetracyclines are a family of antibiotics which are effective in inhibiting the growth of gram-positive and gram-negative bacteria. The mechanism with which they achieve this is by preventing aminoacyl-tRNA from attaching to the A (acceptor) site on the ribosome. This inhibits bacteria from being able to synthesis protein. (Chopra et. al, 2001) In this study, we will examine bacteria from Transect 1 on both nutrient agar plates and nutrient agar plates with tetracycline (tetracycline plates).
We hypothesize that there will be more bacteria growth on nutrient agar plates than on tetracycline plates. If tetracycline is effective in inhibiting bacterial growth, the number of bacteria growing on tetracycline plates should be less than the number growing on nutrient agar plates.
Methods and Materials
The Hay Infusion was observed for changes in smell and appearance.
Bacteria which grew on the eight agar plates inoculated from the Hay Infusion Culture was observed. Colony numbers and morphology were noted.
Two colonies from nutrient agar plates and one colony from a tetracycline plate were chosen for detailed study. Wet mounts of each colony was prepared and observed using a microscope with a magnification of 1000x using an oil immersion lens. Each colony was also Gram stained using the following process: A tiny amount of each colony was transferred to a slide and heat fixed. The bacteria was then stained with crystal violet for 1 minute and rinsed with water; stained with Gram's iodine mordant for 1 minute and rinced with 95% alcohol; and finally stained with safranin stain for 30 seconds and rinsed. The Gram stained slides were observed under the microscope at 100x magnification and characterized
Each colony was also set up for 16s sequencing using PCR. For each colony, the following procedure was conducted: A small amount of the colony was added to 100 ul of water and incubated at 100 degrees Celcius for 10 minutes. The sample was then centrifuged for 5 minutes at 13,400 rpm. 20 ul of primer/water mixture and a PCR bead was mixed with 5ul of the supernatant from the centrifuge. The mixture was placed in the PCR machine overnight.
Results
The appearance of our Hay Infusion Culture remained similar to the previous week. The smell remained odorous and unpleasant.
Table 1 shows the number of colonies which were observed on the four nutrient agar plates and the four nutrient agar and tetracycline plates. In addition to colony numbers, he colony distribution and variety among the nutrient agar and tetracycline plates of the same dilution also appeared similar.
Table 1 Colony Numbers on Nutrient Agar and Tetracycline Plates
| Dilution | Agar Type | Coloines Counted | Conversion Factor | Colonies/ml |
|---|---|---|---|---|
| 10^(-3) | nutrient | lawn | x10^(3) | lawn |
| 10^(-5) | nutrient | 800 | x10^(5) | 8E+07 |
| 10^(-7) | nutrient | 600 | x10^(7) | 6E+09 |
| 10^(-9) | nutrient | 200 | x10^(9) | 2E+11 |
| 10^(-3) | nutrient + tet | lawn | x10^(3) | lawn |
| 10^(-5) | nutrient + tet | 900 | x10^(5) | 9E+07 |
| 10^(-7) | nutrient + tet | 400 | x10^(7) | 4E+09 |
| 10^(-9) | nutrient + tet | 400 | x10^(9) | 4E+11 |
Table 1 shows the number of colonies of bacteria on the nutrient agar and tetracycline plates are similar. Higher numbers of colonies were present for more concentrated dilutions than for less concentrated dilutions, and lawns of bacteria were observed in the 10^(-3) dilution for both nutrient agar and tetracycline plates.
Figure 1 shows a photograph of three colonies which were selected (circled in red wax). On the top row are colonies A and C. On the bottom row is colony B.
Figure 1 Three Bacterial Colonies
Figure 1 shows a photograph of three colonies which were selected and studied.
Table 2 shows the characterization of three bacterial colonies.
Table 2 Characterization of Three Bacterial Colonies
| Colony Label | Plate type | Colony Description | Bacteria Description |
|---|---|---|---|
| A | Nutrient, 10^(-3) | Yellow, circular, convex, even (entire) | Gram -, stained dark orange, spherical, 3.3 um |
| B | Nutrient, 10^(-9) | White, filamentous, convex | Gram +, stained purple, spherical, 10 um |
| C | Tetracycline, 10^(-9) | Yellow, circular, convex, curled | Gram +, stained purple, spherical, 10 um |
Table 2 shows the three bacterial colonies are yellow and white, with a convex shape. Individual bacteria had a circular morphology and a size of between 3.3 um to 10um.
Figure 2 shows the morphology of three bacterial colonies under 100x magnification.
Figure 2 Morphology of Three Bacterial Colonies under 100x Magnification
Figure 2 shows the morphology of three bacterial colonies under 100x magnification.
Discussion
The appearance and smell of our Hay Infusion Culture remained similar this week. However, it is possible that over time, the appearance and smell can change due to increased numbers and diversity of organisms which are present in the Hay Infusion Culture. Further observation is needed to understand the change within this mini ecosystem.
We hypothesized that there will be more bacteria growth on nutrient agar plates than on tetracycline plates. However, the number of bacteria we observed in the nutrient agar and the tetracycline plates were very similar. The colony distribution and variety among the nutrient agar and tetracycline plates of the same dilution also appeared similar. From our results we conclude that tetracycline did not affect the number or variety of bacteria growth. This may be because many bacteria species in Transect 1 have developed antibiotic resistance to tetracycline. Since its discovery in the 1940s, the antibiotic resistance to tetracycline has increased. (Copra et. al, 2001). Further study through PCR analysis of DNA sequences and identification of the bacterial species growing on nutrient agar and tetracycline plates can elucidate whether there were differences we were unable to observe qualitatively.
References
1. Bentley, Walters-Conte, & Zeller. 2014. Biology 210 Laboratory: The Diversity of Life Lab Manual. American University: Washington.
2. Chopra, Ian & Roberts, Marilyn. 2001. Tetracycline Antibiotics: Mode of Action, Applications, Molecular Biology, and Epidemiology of Bacterial Resistance. Microbiology and Molecular Biology Reviews, 65: 232-260.
3. Freeman, Scott. 2014. Biological Science. Prentice Hall: Boston.
Jul 2, 2014
Lab 2: Protists
Introduction
Living organisms on earth can be divided into prokaryotes, eukaryotes, and archaea. Algae and prostists represent two large groups of unicellular eukaryotes. Algae can perform photosynthesis while protists are consumers which obtain nutrients from other organisms. (Bentley et. al, 2014)
In this lab, we aim observe a Hay Infusion Culture of microorganisms from Transect 1 and identify and characterize four microscopic organisms using a dichotomous key. We hypothesize that different organisms can be found in different layers of the Hay Infusion. More specifically, we hypothesize that photosynthesizing microorganisms will be found in the top layer of the Hay Infusion Culture, while non-photosynethesizing microorganisms will be found in the bottom layer.
Materials and Methods
We prepared a Hay Infusion Culture in the last lab (see Lab 1 entry for information on the preparation of the culture). The Hay Infusion Culture was observed. Wet mount slides were prepared with liquid from the top layer of the Hay Infusion Culture and the bottom layer of the Hay Infusion Culture and were observed under the microscope. Four microscopic organisms were identified and characterized using Ward's dichotomous key. (Ward, 2014)
A sample of 100 uls was taken from the shaken Hay Infusion Culture and serially diluted for plating on agar petri dishes with and without tetracycline. 100 uls of Hay Infusion sample was added to 10 mls of sterile broth. 100 uls was transferred to the next 10 mls of sterile broth. This transferring procedure was repeated two more times. With each serial dilution, the Hay Infusion Culture mixture was diluted by 10^2 times. Figure 1 shows the serial dilution process.
Figure 1 Serial Dilution of Hay Infusion Culture
Figure 1 shows the serial dilution procedure of Hay Infusion Culture.
After the serial dilution, the culture and broth mixes were plated onto four agar petri dishes without tetracycline and four agar petri dishes with tetracycline. The petri dishes were left at room temperature to grow for four days.
Results
Figure 2 shows our Hay Infusion Culture.
Figure 2 Transect 1 Hay Infusion Culture
Figure 2 is a photograph of the Hay Infusion Culture from Transect 1.
The Hay Infusion Culture was tan-colored and clouded, with colony-like components floating on top. There was also brown sediment at the bottom. The smell was biotic and unpleasant.
Figure 3 shows four microorganisms which were observed from the Hay Infusion Culture under the microscope at 100x magnification.
Figure 3 Microorganisms in Transect 1 Hay Infusion Culture
Figure 3 shows microorganisms which were observed from the Hay Infusion at 100x magnification.
Two types of algae, gonium and pandorina, were observed from the top layer of the Hay Infusion Culture. Gonium was green and non-motile, with a colony size ranging from 2-10 (20-100 um) under the ocular micrometer. Pandorina was also green and non-motile, with a spherical shape and a size of 10 um.
Two types of protists, arcella and stentor, were observed from the bottom layer of the Hay Infusion Culture. Arcella was colorless and motile, with a size of 20 um. Stentor was brownish with green spots inside, with a size of 250 um.
Discussion
We hypothesized that microorganisms found from the top of the Hay Infusion Culture would be photosynthesizing while microorganisms found at the bottom would not. In this lab, we observed two green algae in the top layer. Their green color from chlorophyll pigments support they are photosynthesizing microorganisms. We observed arcella and stentor from the bottom layer. Arcella is colorless and motile, so it does not have pigments to conduct photosynthesis. Stentor is brownish in color, but notably has green spots, which may have photosynthetic abilities. Further research shows that the green spots observed are actually algae which is in a symbiotic relationship with stentor. (Webb, 2014) In general, our observations supported our hypothesis that photosynthesizing organisms lived near the top layer and non-photosynthesizing organisms lived near the bottom layer.
Organisms must be able to sustain fundamental needs of life. (Freeman, 2014) Gonium presents such an example. It performs photosynthesis, allowing it to acquire energy. Its structure is simple, but it is composed of single cells. It is a eukaryote and contains genetic information for life (not directly observed in this lab). There is also diversity in the species, which provides the opportunity for continual evolution.
If the Hay Infusion Culture had been observed for another two months, we would expect the culture to contain more diversity of organisms. However, the carrying capacity could also be reached by two months, causing some organisms to be unable to survive and reproduce. We would expect photosynthesizing organisms to continue to proliferate, as they are not dependent on others for their food source. Well-adapted protists who are able to secure their food source in competition would also continue to proliferate.
References
1. Bentley, Walters-Conte, & Zeller. 2014. Biology 210 Laboratory: The Diversity of Life Lab Manual. American University: Washington.
2. Freeman, Scott. 2014. Biological Science. Prentice Hall: Boston.
3. Ward's Natural Science. 2014. Free-Living Protozoa. Ward's Natural Science: Rochester.
4. Webb, Howard. 2007. Stentors. Micscape Magazine. Accessed Jul 7 2014 from http://www.microscopy-uk.org.uk/mag/indexmag.html?http://www.microscopy-uk.org.uk/mag/artjul07/hw-stentor.html
Jun 30, 2014
Lab 1: Biological life at AU
Introduction
Life on earth is varied, with more than a million different forms of life currently characterized by scientists. (Bentley et. al, 2014) In this lab, we aim to study a 20 by 20 transect of land on campus at American University. The mini ecosystem is named the mini-marsh (also Transect 1). We hypothesize that the transect will contain multiple forms of life as well as abiotic components.
Materials and Methods
Two lab partners surveyed a transect of land and conducted a comprehensive qualitative analysis of life forms and abiotic components in Transect 1. Transect characteristics including location and topography were also noted.
A 50 ml sample of soil and ground vegetation was brought back to the laboratory to prepare a Hay Infusion Culture. 11.6 g of soil was placed placed in a plastic jar with 500 mls of Deerpark water and 0.1 gm of dried milk. The mixture was mixed and placed in a corner of the lab with an open lid for two days.
Results
Transect 1 is located in front of the Kogod School of Business in the Massachusetts entrance of American University. The topography is slightly raised. Both biotic and abiotic components were observed on the mini-marsh transect, and a variety of plant life was observed. Figure 1 shows an aerial view of the transect.
Figure 1 Aeriel View of Transect 1
Figure 1 shows the aerial view of Transect 1.
Figure 2 Photograph of Left Side of Transect 1
Figure 2 is a photograph of Transect 1 from the left side.
Figure 3 Photograph of Right Side of Transect 1
Figure 3 is a photograph of Transect 1 from the right side.
Plant life on Transect 1 included numerous types of bushes (bushes with white flowers, bushes with berries, a third type of bushes) and grass-like plants (grass, tall grass, weeds, cattails). All plants were flourishing. Abiotic components include a drainage, small rocks, large boulders with different minerals, and a lamp post.
Discussion
We hypothesized that the transect will contain multiple forms of life as well as abiotic components, and our findings were consistent with this hypothesis. In our qualitative analysis, we found a variety of different plants were present on Transect 1. All plants were flourishing, leading us to believe the ecosystem is stable. We also found some abiotic components in the Transect 1. This is probably due to the fact that the transect is located on a university campus built by man.
Further study of additional life forms present in the transect can help increase our understanding of this ecosystem. One limitation of this lab was we used qualitative observations to analyze the transect. Use of microscopes and other bioessay methods could help us better understand and characterize smaller life forms which are also integral to this ecosystem.
Reference
1. Bentley, Walters-Conte, & Zeller. 2014. Biology 210 Laboratory: The Diversity of Life Lab Manual. American University: Washington.